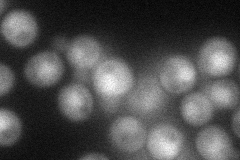

View description
Possible shared subunit of Cop9 signalosome (CSN) and eIF3, binds eIF3b subunit Prt1p, has possible dual functions in transcriptional and translational control, contains a PCI (Proteasome-COP9 signalosome (CSN)-eIF3) domain
Localization:
Intensity:
Fold change:
Significance:
-
C’ GFP library in SD

below threshold18.24 -
N' NOP1pr-GFP in SD
cytosol,nucleus47.1664 -
N' TEF2pr-mCherry in SD

cytosol,nucleus7.74076 -
N' NATIVEpr-GFP in SD

below threshold22.3225 -
N' TEF2pr-VC and Cyto-VN in SD

cytosol27.4319 -
C’ GFP library in SD+DTT

cytosol19.311.05No -
C’ GFP library in SD+H2O2

cytosol201.09No -
C’ GFP library in Starvation Media

cytosol18.431.01No -
C’ GFP library on the background of Pup2-DaMP

N/A -
C’ GFP library on the background of CCT mutant

N/A0N/AYes
